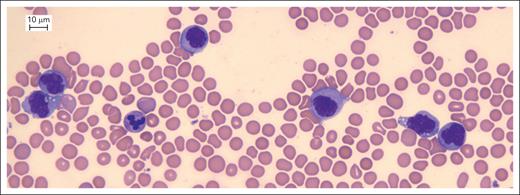
CD371pos BCP-ALL: standard morphology evaluation of a PB sample on day 8 of induction therapy. Standard morphology of a CD371pos BCP-ALL PB sample collected on day 8 of induction therapy revealed a population of monocytes at different maturation stages. Technical information: sample preparation and acquisition at ambient temperature; cytochemical staining: May-Grünwald-Giemsa; microscope model: Leica DM2000 LED (Leica Microsystem Srl, Buccinasco, Milan, Italy); objective: Leica HC PL Fluotar 40× objective (Leica Microsystem Srl); camera model: Leica DMC4500 (Leica Microsystem Srl); picture acquisition software: LAS (Leica Application Suite) version 4.13 (Leica Microsystem Srl).

Pediatric CD371-positive B-cell precursor acute lymphoblastic leukemia shows transient lineage switch and slow early response to treatment.
Accurate immunophenotypic identification of lineage switch is mandatory to properly assess MRD by flow cytometry.
Visual Abstract
In the effort to improve immunophenotyping and minimal residual disease (MRD) assessment in acute lymphoblastic leukemia (ALL), the international Berlin-Frankfurt-Münster (iBFM) Flow Network introduced the myelomonocytic marker CD371 for a large prospective characterization with a long follow-up. In the present study, we aimed to investigate the clinical and biological features of CD371-positive (CD371pos) pediatric B-cell precursor ALL (BCP-ALL). From June 2014 to February 2017, 1812 pediatric patients with newly diagnosed BCP-ALLs enrolled in trial AIEOP-BFM ALL 2009 were evaluated as part of either a screening (n = 843, Italian centers) or validation cohort (n = 969, other iBFM centers). Laboratory assessment at diagnosis consisted of morphological, immunophenotypic, and genetic analysis. Response assessment relied on morphology, multiparametric flow cytometry (MFC), and polymerase chain reaction (PCR)-MRD. At diagnosis, 160 of 1812 (8.8%) BCP-ALLs were CD371pos. This correlated with older age, lower ETV6::RUNX1 frequency, immunophenotypic immaturity (all P < .001), and strong expression of CD34 and of CD45 (P < .05). During induction therapy, CD371pos BCP-ALLs showed a transient myelomonocytic switch (mm-SW: up to 65.4% of samples at day 15) and an inferior response to chemotherapy (slow early response, P < .001). However, the 5-year event-free survival was 88.3%. Among 420 patients from the validation cohort, 27 of 28 (96.4%) cases positive for DUX4-fusions were CD371pos. In conclusion, in the largest pediatric cohort, CD371 is the most sensitive marker of transient mm-SW, whose recognition is essential for proper MFC MRD assessment. CD371pos is associated to poor early treatment response, although a good outcome can be reached after MRD-based ALL-related therapies.
Introduction
Acute lymphoblastic leukemia (ALL) is the most common childhood cancer, accounting for ∼20% of all malignancies in those aged <20 years.1,2 In the last decades, remarkable progress has been achieved in the outcome of children with ALL, the current survival rate being ∼90%.3-5 Nonetheless, relapse still occurs in a significant proportion of patients with ALL and is associated with a poor prognosis.6 Therefore, it is mandatory to appropriately stratify patients and treat them with a tailored therapeutic regimen.
Multiparametric flow cytometry (MFC) is fundamental in the diagnosis and monitoring of ALL treatment response.7-9 Immunophenotypic characterization provides the diagnostic basis to identify and assign blasts to their specific B, T, or myeloid lineage.7 Nowadays, MFC is used in pediatric ALL therapeutic protocols to evaluate the response to therapy and stratify patients into risk groups based on minimal residual disease (MRD) assessment on day 15 of induction therapy (induction).10
Several new markers have recently been introduced in the effort to improve ALL immunophenotype characterization at diagnosis and MFC MRD accuracy. Among them, CD371 (aliases CLL-1, CLEC12A, MICL, KLRL1, or DCAL-2) is a 30 kD type II transmembrane glycoprotein with extracellular C-type lectin domains, belonging to the C-type lectin family.11 It is expressed on normal monocytes, granulocytes, basophils, and most of acute myeloid leukemia (AML) blasts and leukemic stem cells, being recently indicated as a promising target for AML immunotherapy.11-15
In 2014, several national MFC reference laboratories of the international Berlin-Frankfurt-Münster Flow Network (iBFM-FN), including the Associazione Italiana Ematologia Oncologia Pediatrica (AIEOP) reference laboratory in Padua (Padua Laboratory), introduced CD371 in the antibody panel for ALL immunophenotyping at diagnosis. This allowed us to characterize a subset of pediatric B-cell precursor ALLs (BCP-ALL) with aberrant expression of CD371 at diagnosis, recently described as associated with DUX4 rearrangement (DUX4pos).16 We also found that some of these CD371-positive (CD371pos) BCP-ALL cases showed monocytic population early during induction. A similar phenomenon was previously observed in BCP-ALLs with aberrant expression of CD2 antigen and the absence of KMT2A rearrangements; it was interpreted as a transient switch (SW) to the monocytic lineage.17,18 Generally, SW is defined as a lineage variation of blast immunophenotype during first-line therapy17,19 or at relapse,20-22 observed in adults and children.20,21,23 SW is potentially associated with a poor prognosis24 and frequently with KMT2A rearrangements19,25,26 or BCR::ABL1.27 Notably, the SW phenomenon during induction carries a risk of misdiagnosis and/or erroneous interpretation of MFC MRD findings.
These observations prompted us to investigate the clinical and biological features of CD371pos pediatric BCP-ALLs on a consecutive screening cohort from AIEOP and on a validation cohort collected from other iBFM-FN centers.
Methods
Study population and diagnostic workup: screening cohort
From June 2014 to February 2017, 883 children aged 1 year to <18 years with newly diagnosed BCR::ABL1-negative BCP-ALL were consecutively enrolled in the AIEOP-BFM ALL 2009 study (EudraCT Number: 2007-004270-43) in AIEOP Centers.28
According to the protocol, the diagnosis of BCP-ALL was based on morphologic, cytochemical, immunophenotypic, and genetic analysis (karyotype; DNA index; and presence of fusion genes ETV6::RUNX1, TCF3::PBX1, or KMT2A::AFF1).28 Response to therapy was assessed in peripheral blood (PB) on day 8 (morphology), and bone marrow (BM) samples on day 15 (MFC MRD), day 33 (BM morphology and polymerase chain reaction [PCR]-MRD), and day 78 (BM PCR MRD).28 PB and BM specimens were collected and centralized to the reference laboratories for morphology, immunophenotyping, MFC MRD, molecular diagnosis, screening of immunoglobulin/T-cell receptor (IG/TR) rearrangements, and PCR MRD analysis.28 Risk group stratification included 3 subgroups (standard, intermediate, and high) relying on biological features (hypodiploidy and KMT2A::AFF1) and response to therapy on days 8, 15, 33, and 78 (supplemental Table 1, available on the Blood website).28
Local institutional ethical committees approved PB and BM samplings along with the international protocol. In compliance with the Declaration of Helsinki, written informed consent to use excess diagnostic material for research purposes was obtained from parents or guardians.
MFC analysis
PB and BM samples were processed and analyzed in the Padua Laboratory, according to previously described standard operating procedures.7,29,30 We evaluated CD371 expression using CD371-PE (clone 50C1, Becton Dickinson, Franklin Lakes, NJ) for diagnostic immunophenotyping, and CD371-PC5.5 (clone 50C1, BioLegend, San Diego, CA) included in the dry 10-color preformulated DuraClone 10 Color Custom Mix (Beckman Coulter, Inc, Brea, CA) for MFC MRD monitoring.
Briefly, we performed immunophenotyping at diagnosis on erythrocyte-lysed whole BM samples, as previously reported.29 BM samples were sent from AIEOP centers at ambient temperature and processed within 24 hours from collection (for additional details, see MFC analysis section of supplemental Data). We graded antigen expression in negative, weak-positive, strong-positive, and partial-positive, as per the AIEOP-BFM Consensus Guidelines 2016 for ALL immunophenotyping, comparing the fluorescence shift and distribution pattern of the blasts to the appropriate negative control.7,29,31-33
We defined BCP-ALL by the presence of a leukemia population with a strong positivity of at least 2 antigens among CD19, CD10, iCD22, and iCD79a.29,31,33,34 Four immunophenotypic subtypes of BCP-ALL were identified according to European Group for the Immunological Characterization of Leukemias (EGIL) classification (B-I, B-II, B-III, and B-IV).35 We excluded mature B-cell ALL (B-IV) with L3 morphology and Burkitt-type MYC rearrangement, as per therapeutic protocol.28
MFC MRD was performed as previously described30 (see MFC analysis section of supplemental Data) on day 15 (BM) according to the therapeutic protocol28 and experimentally on days 8 (PB), 33 (BM), and 78 (BM) using leftover material whenever available. We defined MRD positivity as a cluster of at least 10 events with lymphoid-scattering properties and leukemia-associated immunophenotypic characteristics, as previously reported.30
To measure DNA ploidy by MFC (DNA index), 500 000 mononuclear cells were stained by propidium iodide and analyzed by flow cytometry, as previously described.8
PCR MRD evaluation
IG/TR gene rearrangements were identified by PCR and used as markers to monitor MRD by real-time quantitative PCR, as previously described.36,37
Briefly, DNA samples obtained at diagnosis were screened for IG/TR rearrangements. We designed allele-specific oligonucleotide primers to complement the junctional region sequence of each target. We tested MRD PCR targets and selected 2 for each patient. A reproducible sensitivity of at least 10−4 was required for at least 1 marker.36,37 We performed and interpreted real-time quantitative PCR analyses according to the European Study Group for MRD detection in ALL (EuroMRD ALL) guidelines.37
Remission induction treatment
Induction IA consisted of a 7-day monotherapy with prednisone and 1 dose of intrathecal methotrexate, then associated with vincristine (4 doses), daunorubicin (4 doses; in patients not at high risk who were either ETV6::RUNX1 positive or with MFC MRD on induction day 15 of <0.1%: randomized 2 vs 4 doses), pegylated asparaginase (2 doses) and intrathecal methotrexate (2 doses for patients with central nervous system 1 [CNS1] involvement, and 4 doses for those with CNS2 and CNS3 involvement; see supplemental Data for the definition of CNS involvement). Remission induction was followed by consolidation phase 1B (consolidation).28
Validation cohort from the iBFM centers
After defining the main features of pediatric CD371pos BCP-ALL in the AIEOP cohort, we built up a data sheet to retrospectively collect data on pediatric BCP-ALL from those iBFM-FN centers that also had integrated CD371 assessment into the diagnostic work-up (Vienna, n = 269; Kiel, n = 537; and Prague, n = 163). The inclusion criteria were (1) enrollment in the AIEOP-BFM ALL 2009 protocol, and (2) use of CD371 monoclonal antibody (mAb) in the panel for immunophenotyping at diagnosis. Data sheets were compiled by each iBFM center according to the sample analysis performed on site and centralized to the Padua Laboratory for data curation and elaboration. Additionally, within the validation cohort, B-other ALLs from the Austrian and Czech cohorts were screened for DUX4pos by RNA sequencing16 or DUX4 positivity was excluded (DUX4neg) by the presence of other subtype-specific genetic alterations detected by fluorescence in situ hybridization, single-nucleotide polymorphism array analysis, real-time PCR, or mutation screening.
Statistical analysis
Descriptive methods were applied to present data, with frequencies and percentages for dichotomous and categorical variables (with categories defined according to standard criteria) and median, range, mean, and standard deviation, as appropriate, for continuous variables. The χ2 or Fisher exact tests for group-wise comparisons of categorical variables were applied (depending on expected cell values >5 or <5), respectively. Two-sided P values <.05 were considered to be statistically significant.
Outcome analysis was based on CD371 status at diagnosis [CD371pos vs CD371-negative (CD371neg)] and performed on the entire group of patients included in the screening and validation cohorts. Event-free survival (EFS) was defined as the time from diagnosis until treatment failure because of death before complete remission, resistance, relapse, death in remission, or second malignancy, whichever occurred first, or until date of the last contact, if failure-free. Cumulative incidence of relapse (CIR) refers to time until relapse, considering all other events as competing events.
The statistical analysis was performed using SAS version 9.4 software (SAS Institute Inc, Cary, NC).
Results
Features of CD371pos BCP-ALL in the AIEOP cohort at diagnosis
Of 883 patients with BCP-ALL enrolled in the study period, 843 (95.5%) were evaluated for CD371 expression at diagnosis. The CD371 antigen was positive in 76 patients (9.0%), of whom 69 were strong-positive, 5 weak-positive, and 2 only partially positive. CD371pos was significantly more frequent among older children (aged ≥10 years; P < .001), and in the presence of DNA index = 1.00 (P < .001). No significant difference in CD371 expression was found according to sex, PB white cell count at diagnosis, and KMT2A::AFF1 rearrangement, whereas an ETV6::RUNX1 fusion gene was detected less frequently in CD371pos than in CD371neg BCP-ALL (P < .001). TCF3::PBX1 rearrangement was not identified in the analyzed CD371pos BCP-ALL cohort (Table 1).
In CD371pos BCP-ALL, the immunophenotype at diagnosis showed an earlier stage of differentiation, as per EGIL classification (P < .001; Table 1). Moreover, CD371 positivity was associated with strong expression of CD34 (P = .013), CD45 (P < .001), and CD58 (P = .014), and the aberrant expression of at least 1 myeloid marker of CD11b, CD14, CD15, CD33, CD64, CD65, iMPO, iLysozyme, CD13, and CD117 (P < .001; Table 2). No differences were observed in the distribution of biphenotypic acute leukemia according to EGIL classification and mixed-phenotype acute leukemia by the World Health Organization definition (Table 1). Finally, we found a significant association between CD371pos BCP-ALL and the aberrant expression of the CD2 antigen (P < .001; Table 2).
MFC MRD evaluation of CD371pos BCP-ALL in the AIEOP cohort
Of the 76 CD371pos BCP-ALLs at diagnosis, 73 samples (96.1%) were evaluable for MFC MRD on day 15 of induction; 3 samples did not reach the minimum of events (acquired nucleated cells) required to obtain an MRD sensitivity threshold of 1 × 10−4 and were excluded from the final analysis. Additionally, we performed MFC MRD analysis during induction in 43 (58.9%) PB samples on day 8, and in 40 (54.8%) and 54 (74.0%) BM samples on day 33 and day 78, respectively. When assessed, CD371 expression was always present with no downregulation in those samples still positive for blasts during induction (39 samples), confirming CD371 as a useful marker for MRD detection in CD371pos BCP-ALL (supplemental Figure 1).
During the first 15 days of induction, we observed in the PB/BM of CD371pos samples the appearance of a population characterized by a strong expression of CD34, CD58, and CD45, downregulation of CD19, and increased side scatter (SSC) signal. This phenomenon was interpreted as a myelomonocytic SW (mm-SW). It displayed 2 different patterns: (1) a single population of blasts with heterogeneous expression of CD19 (strong to weak/negative; Figure 1A); and (2) 2 distinct populations of blast cells, with the first keeping the immunophenotype of diagnosis (unchanged lymphoblasts), and the second showing a downregulation of CD19 and CD34, an upregulation of CD45, and an increase of SSC (SW blasts; Figure 1B). Importantly, in the same samples, morphology assessment always revealed the presence of monocytes at different maturation stages (from monoblasts to mature monocytes), with no clear aberrant morphological features (Figure 2). Moreover, we tested 2 cases of the 2-population–pattern SW samples with an extensive panel including myeloid and monocytic markers: only SW blasts showed positivity of monocytic antigens CD14, CD11b, and CD33, all negative at diagnosis (supplemental Figure 2).
mm-SW in CD371pos BCP-ALL by flow cytometry. With the beginning of steroid treatment as per AIEOP-BFM ALL 2009 protocol, residual lymphoblastic cells showed an mm-SW. It displayed 2 different patterns: (A) a single population of blast cells with heterogeneous expression of CD19 (1-population pattern: orange population); and (B) a 2-population pattern: the first population keeping the immunophenotype of the diagnosis (blue population); the second population showing a downregulation of CD19 and CD34, an upregulation of CD45, and an increase of SSC (orange population). Technical information: fluorochromes: CD19-PC7, CD10-APC/ALEXA700, CD20- V450, CD34-APC, CD58-FITC, CD371-PC5.5, and CD45-V500; sample preparation and acquisition at ambient temperature; sample acquisition: Navios Flow Cytometer (Beckman Coulter, Inc); sample analysis: Software Kaluza 2.1 (Beckman Coulter, Inc). Please see supplemental Data for additional information.
mm-SW in CD371pos BCP-ALL by flow cytometry. With the beginning of steroid treatment as per AIEOP-BFM ALL 2009 protocol, residual lymphoblastic cells showed an mm-SW. It displayed 2 different patterns: (A) a single population of blast cells with heterogeneous expression of CD19 (1-population pattern: orange population); and (B) a 2-population pattern: the first population keeping the immunophenotype of the diagnosis (blue population); the second population showing a downregulation of CD19 and CD34, an upregulation of CD45, and an increase of SSC (orange population). Technical information: fluorochromes: CD19-PC7, CD10-APC/ALEXA700, CD20- V450, CD34-APC, CD58-FITC, CD371-PC5.5, and CD45-V500; sample preparation and acquisition at ambient temperature; sample acquisition: Navios Flow Cytometer (Beckman Coulter, Inc); sample analysis: Software Kaluza 2.1 (Beckman Coulter, Inc). Please see supplemental Data for additional information.
CD371pos BCP-ALL: standard morphology evaluation of a PB sample on day 8 of induction therapy. Standard morphology of a CD371pos BCP-ALL PB sample collected on day 8 of induction therapy revealed a population of monocytes at different maturation stages. Technical information: sample preparation and acquisition at ambient temperature; cytochemical staining: May-Grünwald-Giemsa; microscope model: Leica DM2000 LED (Leica Microsystem Srl, Buccinasco, Milan, Italy); objective: Leica HC PL Fluotar 40× objective (Leica Microsystem Srl); camera model: Leica DMC4500 (Leica Microsystem Srl); picture acquisition software: LAS (Leica Application Suite) version 4.13 (Leica Microsystem Srl).
CD371pos BCP-ALL: standard morphology evaluation of a PB sample on day 8 of induction therapy. Standard morphology of a CD371pos BCP-ALL PB sample collected on day 8 of induction therapy revealed a population of monocytes at different maturation stages. Technical information: sample preparation and acquisition at ambient temperature; cytochemical staining: May-Grünwald-Giemsa; microscope model: Leica DM2000 LED (Leica Microsystem Srl, Buccinasco, Milan, Italy); objective: Leica HC PL Fluotar 40× objective (Leica Microsystem Srl); camera model: Leica DMC4500 (Leica Microsystem Srl); picture acquisition software: LAS (Leica Application Suite) version 4.13 (Leica Microsystem Srl).
Additionally, both unchanged lymphoblasts and SW blasts, when selected by cell sorting, shared identical IG/TR rearrangements with blast cells detected at diagnosis (supplemental Figure 3).
With a detection limit of 1 × 10−4, we identified a mm-SW (mm-SWpos) in 26 of 43 samples (60.5%) on day 8 (PB), 51 of 73 samples (69.9%) on day 15 (BM), and 1 of 40 samples (2.5%) on day 33 (BM). Of the 156 samples analyzed by MFC MRD on days 8, 15, and 33, 73 and 5 displayed the 2-population or 1-population mm-SW, respectively (see supplemental Table 2 for details). In our cohort, no SW (mm-SWneg) was observed on day 78 (BM; Table 3). Of note, chemotherapy was always administered as per AIEOP-BFM ALL 2009 protocol. Of 26 samples mm-SWpos on day 8, 25 (96.2%) were still mm-SWpos on day 15, and 1 also on day 33. Of the 17 mm-SWneg samples on day 8, 6 (35.3%) turned into mm-SWpos on day 15 (Figure 3).
mm-SW evolution during induction and consolidation therapy as per AIEOP-BFM ALL 2009 protocol. Of 73 CD371pos BCP-ALL samples evaluable for MFC MRD from the screening cohort (AIEOP), the mm-SW was observed (detection limit, 1 × 10−4) since the first reevaluation time point on day 8 or later on day 15 and day 33. It was never detected on day 78 in the screening cohort. N, number of samples; SW+, presence of lineage SW; SW−, absence of lineage-SW population; SW NA, MCF-MRD not available.
mm-SW evolution during induction and consolidation therapy as per AIEOP-BFM ALL 2009 protocol. Of 73 CD371pos BCP-ALL samples evaluable for MFC MRD from the screening cohort (AIEOP), the mm-SW was observed (detection limit, 1 × 10−4) since the first reevaluation time point on day 8 or later on day 15 and day 33. It was never detected on day 78 in the screening cohort. N, number of samples; SW+, presence of lineage SW; SW−, absence of lineage-SW population; SW NA, MCF-MRD not available.
A transient mm-SW was observed also in 4 of 767 (0.5%) CD371neg BCP-ALLs, all showing an immunophenotype only partially overlapping (B-II ALL; absence of CD371 and CD2; weaker expression of CD45) with CD371pos samples.
CD371 and CD2 positivity at diagnosis predicts mm-SW
Although there was a significant association between CD371 and CD2 expression at diagnosis (P < .001), in our cohort, CD2 was detected in 50.0% of the CD371pos samples (Table 2).
We analyzed CD371 and CD2 independently to understand which antigen at diagnosis could better predict the mm-SW (supplemental Table 3). Of the 41 CD2pos BCP-ALLs at diagnosis, 31 (75.6%) showed a mm-SW on day 15: all of them were CD371pos. Of 789 CD2neg samples at diagnosis, 24 (3.0%) presented a mm-SW on day 15, and these were all CD371pos.
Only 4 of 757 (0.5%) samples from CD371neg BCP-ALL at diagnosis showed a mm-SW on day 15; and notably all of them were CD2neg.
Consequently, in the AIEOP cohort, CD371 was more sensitive than CD2 (sensitivity 0.93 vs 0.56) in predicting a mm-SW on day 15, with a similar specificity (0.97 vs 0.99).
Response to the induction and consolidation therapy and final risk grouping
CD371pos BCP-ALL exhibited a worse early response to chemotherapy according to AIEOP-BFM ALL 2009 protocol as compared with CD371neg BCP-ALL, based on MRD evaluation on days 15, 33 (TP1), and 78 (TP2; Table 4). A significantly higher proportion of patients with CD371pos vs CD371neg were enrolled in the final high-risk therapeutic arm (P < .001), mainly because of a significantly higher proportion of patients classified as slow early responders (MRD-SER; P < .001; Table 4; see supplemental Table 4 for details).
Validation cohort from the iBFM-FN
A total of 969 pediatric patients with newly diagnosed BCP-ALL (median age, 5.1 years; range, 1 to <18 years) were enrolled in this study from the other iBFM-FN centers. Of these, 84 (8.7%) were CD371pos, and 885 (91.3%) were CD371neg at diagnosis. As in the screening cohort, CD371pos at diagnosis was associated with older age, a peculiar immunophenotype, absence of TCF3::PBX1 and ETV6::RUNX1 rearrangements, and no differences in the distribution of sex and KMT2A::AFF1 rearrangement compared with CD371neg ALLs (Tables 2, 4, and 5).
During induction and consolidation, MFC MRD was assessed in 165 samples collected at different reevaluation time points from patients with BCP-ALL with CD371 positivity at diagnosis, of whom 68 (41.2%) showed mm-SW (day 8: 16 of 21 samples [76.2%]; day 15: 49 of 80 samples [61.3%]; and day 33: 3 of 32 samples [9.4%]). No SW was detected on day 78 (Table 3).
The iBFM-FN cohort confirmed the association between CD371pos BCP-ALL and a worse response to induction and consolidation (Table 4). Of note, the iBFM-FN CD371pos BCP-ALLs showed a higher proportion of high risk by morphology on day 8, MFC MRD on day 15, and PCR-MRD on day 33/day 78 than AIEOP samples. Because the 2 cohorts included patients consecutively enrolled in the same therapeutic protocol with no selection biases, these differences, not present in the CD371neg subgroup, could reasonably depend on the small number of samples of the CD371pos subgroups.
Finally, of a total of 420 samples, 27 of 28 DUX4pos vs 7 of 387 DUX4neg samples were CD371pos, confirming CD371 as a sensitive and specific surrogate immunophenotype marker of DUX4pos in BCP-ALLs (supplemental Table 5).
Outcome analysis
In a total of 1796 patients (158 CD371pos and 1638 CD371neg at diagnosis) from the screening and validation cohorts, the 5-year EFS was 88.3% in CD371pos vs 82.4% in CD371neg BCP-ALLs (P = .07), with a 5-year cumulative incidence of relapse of 6.4% vs 14.3%, respectively (P = .006; Figure 4; supplemental Figure 4). Analyzing separately patients enrolled in the final high-risk (390 patients) and non–high-risk (standard and intermediate risk, 1406 patients) groups, the 5-year EFS was always superior in CD371pos BCP-ALLs but significantly so only in the high-risk group (supplemental Figure 5).
Outcome analysis of CD371pos vs CD371neg BCP-ALL. In a total of 1796 patients (158 CD371pos and 1638 CD371neg at diagnosis) from the screening and validation cohorts, the 5-year EFS was 88.3% in CD371pos BCP-ALLs vs 82.4% in CD371neg BCP-ALLs (P = .07).
Outcome analysis of CD371pos vs CD371neg BCP-ALL. In a total of 1796 patients (158 CD371pos and 1638 CD371neg at diagnosis) from the screening and validation cohorts, the 5-year EFS was 88.3% in CD371pos BCP-ALLs vs 82.4% in CD371neg BCP-ALLs (P = .07).
Finally, when we performed outcome analysis without high hyperdiploid and ETV6::RUNX1-positive samples, both 5-year EFS and cumulative incidence of relapse were significantly better in CD371pos BCP-ALLs (supplemental Figure 6).
Discussion
This is, to our knowledge, the first study that extensively describes the biological and clinical features of a large multicenter cohort of CD371pos BCP-ALLs. CD371 is usually expressed on normal monocytes, granulocytes, basophils, most AML blasts, and leukemia stem cells.11-14
In our cohort, CD371 positivity at diagnosis identified a specific subtype of BCP-ALL, with peculiar clinical and biological features accounting for ∼9.0% of pediatric patients with BCP-ALL. First, CD371pos BCP-ALL was not associated with any of the traditional high-risk features of BCP-ALL at diagnosis, including hypodiploidy, KMT2A::AFF1 rearrangement, or hyperleukocytosis. We did not analyze a potential association between CD371 positivity at diagnosis and BCR::ABL1, being an exclusion criterion from the AIEOP-BFM ALL 2009 protocol. CD371pos BCP-ALL was more frequent in children aged ≥10 years, which is not a high-risk criterion in AIEOP-BFM ALL 2009 protocol.
The immunophenotype at diagnosis showed some peculiarities. A considerable proportion of CD371pos BCP-ALL (13.2%) belonged to the immature group B-I ALL as per EGIL classification and there was a trend toward weaker CD10 expression among EGIL B-II cases (data not shown). CD371pos BCP-ALL showed a brighter intensity of CD34, CD45, and CD58 at diagnosis than CD371neg cases. Altogether, these peculiar features suggest more immaturity and a potentially higher plasticity of CD371pos BCP-ALL, with a propensity to mm-SW under therapeutic pressure.
In our study, with all AIEOP and other iBFM-FN cases cumulated, we observed a mm-SW in 42 of 64 (65.6%) available CD371pos samples on day 8, 100 of 153 (65.4%) samples on day 15, and 4 of 72 (5.6%) samples on day 33, whereas we did not detect it on day 78 (Table 3). The mm-SW was characterized by downregulation of CD19 and CD34, further upregulation of CD45, increase of SSC, and strong expression of CD58. These changes appear to be related to the more general phenomenon of antigen expression modulation induced by ALL therapy, described previously.38-41 Considering its potential impact on MFC MRD analysis and the resulting risk group assignment, we established a systematic approach to optimize SW detection and increase reproducibility. Indeed, the assessment of mm-SW during MRD monitoring is challenging. We classified the mm-SW in 2 distinct patterns: a 1-population and a 2-population pattern. When 1-population was detected, it shared antigens of BCP and myelomonocytic lineages, with a change in lymphoid antigen expression levels (SW-blasts only). More challenging was the detection of the 2-population pattern (consisting of SW-blasts and unchanged lymphoblasts) and its impact on MFC MRD quantification on day 15.
These observations led to 2 clinically relevant questions. First, whether the SW-blast population (CD19 downregulated, CD45 bright) should be considered as part of blasts and included in MFC MRD quantification. Based on our findings, we recommend including it in the MFC MRD final blast count on day 15. This choice is because of the consideration that the mm-SW immunophenotype suggested a direct link with lymphoblasts, keeping, although downregulated, CD19 positivity. Additionally, we demonstrated that SW-blasts and unchanged lymphoblasts shared the same IG/TR rearrangements. Because the mm-SW blast population proportion varied widely, its appearance may deeply influence the final extent of MFC MRD on day 15 and consequently risk group definition. In addition, standard morphology (eg, at day 8) may underestimate blast amount in the presence of a population of monocytes at different maturation stages, lacking clear malignant morphological features (Figure 2).
The second question is whether chemotherapy should be changed to a myeloid leukemia schema in the presence of a preponderant mm-SW blast population. This option was never considered, neither in the AIEOP nor in the iBFM-FN groups, attributing the origin of the SW-blast population to lymphoblastic cells. This choice is supported by treatment strategies described by Hrusak et al42 for ambiguous lineage leukemias.
Importantly, the mm-SW does not constitute a permanent and complete SW to the myeloid lineage as in KMT2A-rearranged ALLs but is always transient, characterized by the coexpression of B- and MM-lineage immunophenotypic features, and limited to the first phase of induction. Therefore, chemotherapy was always continued according to ALL treatment with no shift to AML protocol, differently from what generally considered for KMT2A-positive SW cases.19,25,26 However, CD371pos BCP-ALLs showed a slower response to the induction in comparison with CD371neg BCP-ALL. The significantly higher rate of patients enrolled in the final high-risk therapeutic arm well described this phenomenon. Furthermore, the high incidence of MRD-SER in the evaluation of PCR MRD on days 33 and 78 was a special feature of CD371pos BCP-ALLs. These findings suggest both a reduced sensitivity of CD371pos blasts to the drug combination administered during the first phase of treatment, and the driving role of steroid therapy in the mm-SW.
Notably, CD371 expression in BCP-ALL was found very recently to be strongly associated with DUX4pos,16 and a good long-term outcome.43-45 Our study clearly confirmed the association between CD371 strong positivity and the DUX4pos subtype whereas a weak expression of CD371 was observed with other genotypes. Additionally, our survival analysis showed a good prognosis in the CD371pos subgroup, even in the high-risk group, always continuing on ALL-directed therapy without any changes to a myeloid-oriented treatment. Therefore, our study supports the hypothesis of a direct biological link between DUX4pos and CD371 strong expression. This makes CD371 a suitable immunophenotype surrogate marker to identify blasts with a specific genetic lesion and biological behavior, potentially requiring a more intense treatment to reach a good long-term prognosis, similar to what has been described in early T-cell precursor ALL.46 Regarding the mm-SW, it was observed also in CD371 weak-positive BCP-ALLs in our cohorts and rarely in CD371neg cases. Therefore, further studies are necessary to define the biological role of CD371 expression and DUX4pos in mm-SW.
The inferior response to induction highlights the importance of detecting accurate predictors of mm-SW. Slamova et al17 associated lineage SW with the aberrant expression of CD2 at diagnosis. Consequently, we investigated which marker, CD2 or CD371, might better predict this phenomenon. In the AIEOP cohort, despite both antigens showing high accuracy, CD371 was a more sensitive predictor of mm-SW than CD2. Therefore, we believe that detecting CD371pos BCP-ALL at diagnosis and accurately monitoring MFC MRD on day 15 is still critical for precociously identifying a subgroup of pediatric leukemia with the tendency to an inferior response to induction and consolidation, and providing useful information for a more accurate prognostic communication to patients’ caregivers. This said, considering the overall favorable outcome of pediatric CD371pos BCP-ALL, further studies are necessary to establish whether the advancement in genomics and MRD techniques will confirm the role of the day 15 time point for risk group stratification in this leukemia subtype.
Our study had some limitations. We used different mAb panels for MFC MRD detection in different time periods. Moreover, MFC MRD mAb panels did not include monocyte-lineage markers like CD14, CD15, CD64, and CD11b/c. The introduction of some of these markers may help discriminate the SW-blast population from normal monocytic counterparts.
In conclusion, in the largest pediatric cohort, to our knowledge, described so far, we comprehensively described the biological and clinical features of CD371pos BCP-ALLs characterized by a potential mm-SW during the first phase of induction. Accurate identification of mm-SW is mandatory to properly assess MFC MRD on day 15 in patients with CD371pos disease. This is of particular importance because, in our cohort, CD371pos BCP-ALLs showed a slower response to induction and led to a higher rate of patients included in the high-risk therapeutic group than CD371neg BCP-ALLs. Expression of CD371 antigen is an accurate predictor of mm-SW in BCP-ALL, with high sensitivity and specificity. Chemotherapy should be continued according to an ALL therapeutic protocol even in the presence of a prevalent SW-blast population during the mm-SW, a statement supported by the favorable outcome of CD371pos BCP-ALL shown herein.
Finally, based on our findings, we suggest the introduction of CD371 assessment in both BCP-ALL immunophenotyping at diagnosis and during MFC MRD monitoring.
Acknowledgments
The authors thank Giampietro Viola for performing DNA-index analysis; Daniela Silvestri for the critical contribution to data analysis; all patients and their families, and clinical teams involved in this study; Fondazione CARIPARO; Fondazione Città della Speranza; and Fondazione M. Tettamanti De Marchi for their support. This study was conceived and pursued by the iBFM-FN.
This work was supported by grants from the Fondazione Cariparo (grant/award numbers: FCR 20/12; B.B.), the Anniversary Fund of the Oesterreichische Nationalbank (OeNB 18281; S.S.), and the Czech Ministry of Health (NU23-05-00353; E.M.).
Authorship
Contribution: B.B., G.B., and M.N.D. conceptualized the study; B.B., E.V., G.B., and M.N.D. performed formal analysis; B.B., G.G., M.B., G. Cazzaniga, O.H., S.S., D.S., M. Zaliova, L.K., J.-P.B., T.F., G. Cario, J.A., A.M., A. Biffi, R.P., F.F., A. Biondi, F.L., A.A., M.S., V.C., G.B., and M.N.D. were responsible for patient management and data collection; M.M.-G., A.S., E.M, G. Cazzaniga, M.S., and P.S. were responsible data curation; M. Zimmermann and M.G.V. were responsible statistical analysis; B.B. and E.V. were responsible for preparation of the original manuscript draft; B.B., E.V., F.L., V.C., A.M., G.B., and M.N.D. were responsible for review and editing of the manuscript; E.V. and M.G.V. were responsible for figure preparation; B.B., G.B., and M.N.D. supervised the study; B.B., G.B., and M.N.D. were responsible for project administration; B.B., E.M., and S.S. were responsible for funding acquisition; and all authors have read and agreed to the published version of the manuscript.
Conflict-of-interest disclosure: M.B. received personal fees from Incyte and Roche Pharma AG (advisory board); received financial support for reference diagnostics from Affimed and Regeneron; reports grants and personal fees from Amgen (advisory board, speakers bureau, and travel support); and reports personal fees from Janssen (speakers bureau), all outside the submitted work. The remaining authors declare no competing financial interests.
Giuseppe Basso died on 16 February 2021.
Correspondence: Barbara Buldini, Pediatric Hematology, Oncology and Stem Cell Transplant Division, Maternal and Child Health Department, University of Padua, Via Giustiniani 3, 35128 Padua, Italy; email: barbara.buldini@unipd.it.
References
Author notes
G.B. and M.N.D. contributed equally to this study.
Data are available on request from the corresponding author, Barbara Buldini (barbara.buldini@unipd.it).
The online version of this article contains a data supplement.
The publication costs of this article were defrayed in part by page charge payment. Therefore, and solely to indicate this fact, this article is hereby marked “advertisement” in accordance with 18 USC section 1734.